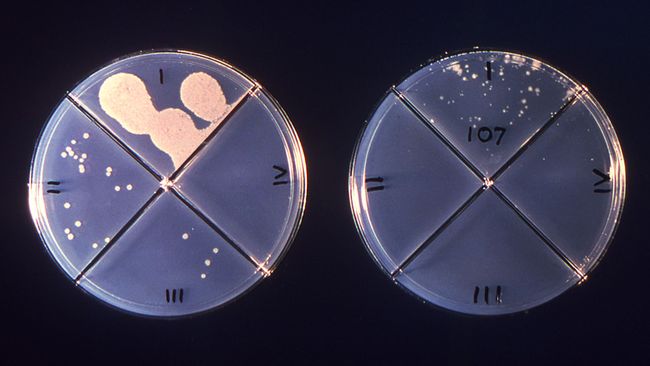
The Chipotle Outbreak That Sickened Nearly 650 People Was Caused By This Bacteria

The Chipotle Outbreak That Sickened Nearly 650 People Was Caused By This Bacteria
Executive Summary
Welcome to our deep dive into The Chipotle Outbreak That Sickened Nearly 650 People Was Caused By This Bacteria. We've gathered 10 relevant articles and 8 images, along with 7 associated subjects to help you explore The Chipotle Outbreak That Sickened Nearly 650 People Was Caused By This Bacteria thoroughly.
People searching for "The Chipotle Outbreak That Sickened Nearly 650 People Was Caused By This Bacteria" are also interested in: Chipotle — Order Now, Chipotle Mexican Grill, CHIPOTLE MEXICAN GRILL, and more.
Visual Analysis
Data Feed: 8 UnitsIntelligence Data
Order tacos, burritos, salads, bowls and more at Chipotle Mexican Grill. Order online for pick up or delivery and join our rewards program today.
Chipotle Mexican Grill, Inc. (/ tʃɪˈpoʊtleɪ / chih-POHT-lay), [3] often known simply as Chipotle, is an American multinational chain of fast casual restaurants specializing in bowls, tacos, and …
Dec 21, 2025 · • Low gift card balance? Split the payment with another card. • Pay your way with Google Pay. • See your sustainability impact with Real Foodprint metrics. • Start a Group …
Sep 2, 2025 · The most updated Chipotle Menu Guide with verified prices for 2026, we manually research menu updates, limited-time offers, and new items so you can plan your meal smarter. …
Download Chipotle by Chipotle Mexican Grill on the App Store. See screenshots, ratings and reviews, user tips, and more games like Chipotle.
Specialties: Chipotle Donelson Pike is a fast-casual restaurant chain known for its customizable menu featuring burritos, bowls, quesadillas, tacos, and salads. The company is cultivating a …
Browse all Chipotle Mexican Grill restaurants in the United States to enjoy responsibly sourced and freshly prepared burritos, burrito bowls, salads, and tacos.
Check out the Chipotle Mexican Grill menu. Plus get a $10 off Grubhub coupon for your first Chipotle Mexican Grill delivery!
4 days ago · Chipotle Launches 4-Ounce Bowl of Meat for the Ozempic Age The move signals that we’re about to see a lot more GLP-1-centric menus.
The Chipotle menu offers a customizable dining experience with fresh ingredients and advanced flavors. Customers can choose from burritos, bowls, tacos, and salads, personalizing each …
Helpful Intelligence?
Our AI expert system uses your verification to refine future results for The Chipotle Outbreak That Sickened Nearly 650 People Was Caused By This Bacteria.